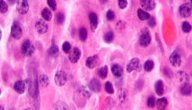

محتويات
الأجسام المضادة
ما هي الأجسام المضادة؟
يطلق على البروتينات التي تنتجها خلايا البلازما والتي هي نوع من أنواع خلايا الدم البيضاء الأجسام المضادّة، وتقوم هذه البروتينات بعمل استجابة مناعيّة في جسم الأنسان، ويتم تحفيز إنتاجها بواسطة مولّدات الضد، حيث تقوم هذه الأجسام المضادة بالارتباط مع مولدات الضد لتدميرها مباشرة أو تسهيل القضاء عليها بواسطة خلايا الدّم البيضاء، وتجدر الإشارة هنا إلى أنّ كل جسم مضاد يرتبط بنوع مستضد واحد خلال هذه العملية،[١] ,وذلك لأنّه يتم تصنيع الأجسام المضادة بطريقة تجعلها محدّدة بشكل دقيق فقط لمولد الضّد، بحيث ترتبط معه وتتفاعل كيميائيًا،[٢] لم يكن مصطلح الأجسام المضادة موجود قبل عام 1901، وكانت تعرف قبل ذلك على أنها مجموعة من المواد المختلفة التي تكافح العدوى ومضاعفاتها على جسم المريض وأنّها بمثابة جنود في الجسم، سيتم بيان ما هي الأجسام المضادة وأنواعها وكيف تعمل داخل الجسم والاستخدامات الطبية لها في هذا المقال.[٣]
إنتاج الأجسام المضادة
كيف يتم إنتاج الأجسام المضادة؟
بعد الحديث بإيجاز عن الأجسام المضادة وإنتاجها، لا بد من التطرق للكيفية التي يتم إنتاجها فيها بشيءٍ من التفصيل؛ حيث تبدأ عملية إنتاج الأجسام المضادة عندما يدخل جسم الأنسان كائنات غريبة كالفيروسات والبكتريا، وتشمل عملية الحرب مع هذا الجسيمات إنتاج خلايا B وقيامها بإطلاق الأجسام المضادة ليتم القضاء على الأجسام الغريبة، وتتم علمية تدمير مسبّبات المرض بواسطة تغليفها ومنعها من دخول خلايا الجسم السليمة، ويستطيع جهاز المناعة معرفة الأجسام الغريبة لأن الجزيئات الموجودة على سطح المستضد تختلف عن الموجودة في الجسم وعند ارتباط مولد الضد من الجسم الغريب مع خلايا B يحفزها على الانقسام، بحيث تنتج خلايا البلازما والتي بدورها تفرِز في مجرى الدم والجهاز اللمفي ملايين المضادات.[٤]
أنواع الأجسام المضادة
ما هي أنواع الأجسام المضادة؟ وما وظائفها؟
في معرض الحديث عن الأجسام المضادة تجدر الإشارة بنا لبيان أنواعها؛ فللأجسام المضادة عدة أنواع، بحيث يُحدّد المكان الذي ستعمل به الأجسام المضادة في الجسم نوعها، ولكل فئة من فئاتها وظيفة خاصة بها، ويوجد خمسة أنواع من الأجسام المضادة وهي IgM ,IgA ,IgG, IgE, IgD، ويمثل مصطلح Ig الجلوبين المناعي، ويعتبر نوع IgG هو النوع الذي يتم بناؤه بواسطة التطعيم والتلقيح أو اكتساب مناعة من إصابة، ويساهم في القضاء على بعض أشكال العدوى وعلى إيقاف تأثير بعض السموم في الجسم، ويمثل التالي أهم أنواع الأجسام المضادة:[٥]
- IgA: ويوجد هذا النوع في المناطق المخاطية، كالمهبل والتجويف الفموي، كما ويمكن العثور عليه في اللعاب والدموع وحليب الثدي، وقد يرتبط هذا الجسم المضاد بأهداف داخل الجسم كما في مرض سيلياك الهضمي ويسبب أمراض مناعية.
- IgM: وهو النوع الذي يتم إنتاجه مباشرة حال دخول البكتيريا أو الفيروس أو الجسم الغريب، وقد يظهر أيضًا نتيجة لتنشيط عدوى قديمة كما في فيروس الهربس، كما يمكن أن يظهر مع مرض تم التخلص منه سابقًا.
- IgE: ويعتبر هذا النوع مسؤول عن الاستجابة التحسسية، ويتواجد في الرئتين والجلد والأغشية المخاطيةّ، وعندما يرتبط مع مسبب الحساسية ينشط تفاعل الهستامين المسؤول عن ظهور أعراض الحساسيّة لدى المريض، كما أنّ لهذا النوع من الأجسام المضادة دور في الحماية من الديدان الطفيليّة.
- IgD: وله دور في المراحل الأولى من الاستجابة المناعيّة، ويعتبر هذا النوع أقلّ نوع من الأجسام المضادة، ولا تزال الدراسات قائمة لاكتشاف وظائفه.
آلية عمل الأجسام المضادة
كيف يتم عمل الأجسام المضادة؟
تعمل الأجسام المضادة كجزء من جهاز المناعة ومن الأدوات المهمّة في الدفاع عن الجسم، فكما سبق ذكره بعد دخول أجسام غريبة للإنسان والتعرف عليها عن طريق خلايا متخصصة تبدأ استجابة مناعية بإنتاج الأجسام المضادّة بمختلف أنواعها لترتبط مع الجسم الغريب وتدمّره، وهناك مناعة فطريّة يكون وُلد فيها الأنسان كما أنّ هناك مناعة مكتسبة، وتتضمن المناعة غير المكتسبة حواجز تمنع دخول الأجسام الغريبة وتمثل خط المناعة الأول عند الكائن الحي وتشمل رد فعل السعال والدموع والمخاط وحمض المعدة وغيرها.[٦]
وعندما يتم تجاوز هذه الخطوط المناعية الأوليّة، يتم تنشيط الاستجابات المناعية المكتسبة، فالتعرض المستمر للمستضدات يجعل جهاز المناعة يبني أجسام مضادة ضد هذه المستضدات، وتجدر الإشارة هنا إلى أنّ للمناعة المكتسبة عدة أنواع كالمناعة المكتسبة السلبية، وتكون عندما يتم إنتاج الأجسام المضادة في جسم غير جسم المريض، ومثالها حصول الطفل عبر المشيمة على الأجسام المضادة من الأم، وغالبًا من تختفي هذه الأجسام المضادة ما بين 6 - 12 شهر من الولادة، كما ويعد حقن المصل مثالًا عليها أيضًا، ويوفر حماية فورية ضد المستضد ولكن لا تكون طويلة الأمد ومثالها ما يعطى لالتهاب الكبد ومضاد سموم الكزاز.[٦]
الاستخدامات الطبية للأجسام المضادة
ما المجالات الطبية التي تستخدم بها الأجسام المضادة؟
بعد فهم ما هي الأجسام المضادة وكيفية عملها وأنواعها، يجب التحدث عن بعض المجالات الطبية التي يتم استخدامها فيها، فقبل اكتشاف اختبارات الحمض النووي لمسبّبات المرض والتي ما زالت لم تلاقى انتشارًا واسعًا ومثالها PCR، كان ولا زال البحث عن استجابة الأجسام المضادة مفيدًا لتشخيص الأمراض خاصةً المنقولة جنسيًا وأسهل من البحث عن مسبب المرض نفسه، خاصةً بأنّ بعض المسبّبات المُمْرضة من أنواع الفيروسات والبكتيريا يصعب نموّها باختبار الزراعة.[٥]
ومن الأمثلة التي لا يزال استخدام الأجسام المضادة لتشخيصها هو مرض الهربس، حيث يمكن استخدام هذا الاختبار للكشف عن الإصابة بعدوى جديدة أو قديمة، وذلك لأن وجود المضاد IgM يعني الإصابة بعدوى جديدة، أما وجود IgG فيعني أنّ الإصابة قديمة، ويعزى ذلك إلى أنّ IgG يحتاج مدة زمنية طويلة لكي يتم إنتاجة مقارنة ب IgM الذي يتم إنتاجه مع بداية دخول الكائن الغريب المسبب للمرض، ومما سبق يمكن اعتبار أنّ للأجسام المضادة دور في تشخيص الأمراض[٥] ودور في علاج بعض الحالات كالتهاب الكبد والكزاز.[٦]
المراجع[+]
- ↑ "antibody", www.cancer.gov, Retrieved 2020-05-16. Edited.
- ↑ "antibody", www.sciencedirect.com, Retrieved 2020-05-16. Edited.
- ↑ "Medical Definition of Antibody", www.medicinenet.com, Retrieved 2020-05-16. Edited.
- ↑ "antibody", www.britannica.com, Retrieved 2020-05-16. Edited.
- ^ أ ب ت "What Are the 5 Types of Antibodies?", www.verywellhealth.com, Retrieved 2020-05-16. Edited.
- ^ أ ب ت "Immune response", medlineplus.gov, Retrieved 2020-05-16. Edited.